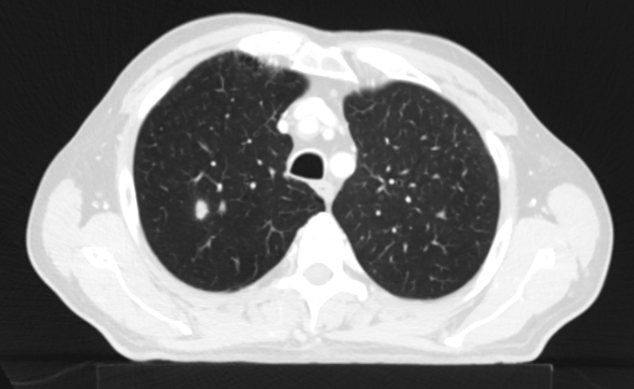
Řez plicemi z CT screeningu: Kontrolní  CT plic před zahájením léčby pembrolizumabem v 10/2021

Kazuistika pacienta s diseminovaným karcinomem močového měchýře do plic, který byl léčen pembrolizumabem ve II. linii s efektem kompletní remise.

MUDr. Jiří Navrátil, Ph.D., Masarykův onkologický ústav a LF MU
71 letý pacient s nově zjištěným tumorem močového měchýře přichází v 1/2021 na doporučení externího pracoviště k provedení radikální cystektomie. Extramurálně byla provedena transuretrální resekce tumoru močového měchýře (TURT) s nálezem High Grade uroteliálního karcinomu minimáně pT2. Na CT břicha a pánve byly popsány zmnožené drobné uzliny v pánvi, RTG plic nebyl dodán.
V roce 2016 pacient podstoupil radikální prostatektomii pro karcinom prostaty, ale bližší dokumentace chybí, PSA v 2/2021 0,02 ug/l. Pacient je celoživotní kuřák, bez alergií. Léčí se dlouhodobě pro CHOPN 3B s emfyzémem, pro které užívá trvale Prednison 10mg. Jinou medikaci neužívá. Dále sledován pro mírnou chronickou renální insuficienci s GFR 0,9 ml/s.
Pacient prošel multidisciplinární komisí, kde bylo onemocnění uzavřeno jak cT2 cN1 Mx s patologickou uzlinou v pánvi. Ale pro drobné plicní nodularity na bazích plic bylo doporučeno doplnit FDG PET/CT, které prokázalo patologické uzliny v pánvi a vícečetné plicní metastázy včetně ložiska v levém plicním hilu. Byla doplněna i bronchoskopie, která neprokázala bronchogenní tumor, bronchiální cytologie negativní. V klinickém obraze se začínal rozvíjet mírný lymfedem obou dolních končetin. Dle prediktivního vyšetření TPS negativní, exprese PDL-1 méně než v 1% nádorových buněk, CPS pod 10. Celkově je pacient PS 1, občasné exacerbace CHOPN, dušnost při námaze, veden na plicní ambulanci.
Do I. linie léčby byla indikována paliativní chemoterapie v režimu CBDCA/gemcitabin, cisplatina pro renální insuficienci a komorbidity nebyla možná. Dávka prednisonu snížena na 5mg. Léčba byla zahájena v 2/2021. Pro trombocytopenii G1 a neutropenii G3 byla nutná podpory růstovými faktory G-CFS a redukce dávek cytostatik až o 30%. Během léčby došlo postupně k regresi a vymizení lymfedemu dolních končetin. Na CT trupu v 5/2021 popsána regrese ložisek plic i uzlin v hilech plic. Po 6 sériích chemoterapie v 9/2021 ale dochází již k progresi jedno z plicních ložisek. V 11/2021 byla provedena paliativní RT na oblast metastatického postižení levé plíce v dávce 10x4Gy, vše bez komplikací.
Do druhé linie léčby byl zvolen pembrolizumab. Léčba byla zahájena v 10/2021 a byla velmi dobře tolerována. Pacient si stěžoval pouze na mírnou únavu. Na prvním kontrolmím přešetření v 1/2022 byla popsána výrazná regrese metastatického postižení plic. Léčba pokračovala bez komplikací, na dalších přešetřeních až do 8/2022 popsána pokračující regrese plicního postižení. Od 11/2022 se jednalo již o stabilizaci reziduálního plicního postižení. Léčba pembrolizumabem pokračovala po dobu 2 let do 9/2023 a v současné době trvá téměř kompletní remise nemoci.
V průběhu léčby pembrolizumabem se střídala intenzita potíží s CHOPN, ataky dušnosti, kašle a zahlenění. Na CT plic byl po 2 sériích imunoterapie popsán plicní infiltrát na plicní bazi vlevo. Diferenciálně diagnosticky uvažováno hlavně o pneumonitis. Klinicky měl pacient drobný suchý kašel, trvající několik týdnů, ale bez vývoje. Imunoterapie pokračovala bez přerušení, klinický stav pacienta byl stabilní, plicní infiltrát postupně samovolně regredoval. Na doporučení pacient změnil plicního specialistu. Byla provedena spirometrie s nálezem těžké obstrukce s lehkou poruchou difúze. Byl vysazen prednison, upravena plicní medikace a potíže s CHOPN výrazně ustoupily. Pacient pracuje, trvá mírná námahová dušnost, PS1. Stran nádoru močového měchýře je zcela asymptomatický.
Závěr
Kazuistika potvrzuje efektivitu léčby pembrolizumabem u polymorbidního 73 letého pacienta s diseminovaným karcinomem močového měchýře a důležitost multioborové spolupráce při správné komplexní onkologické léčbě.
Obrazové přílohy


Obr. 1 – Stagingové PET/CT v 2/2021 potvrzuje plicní diseminaci.

Obr 2. – Kontrolní CT plic před zahájením léčby pembrolizumabem v 10/2021.


Obr 3. – Kontrolní CT plic po 2 sériích léčby pembrolizumabem v 1/2022.


Obr 4. – CT plic z 11/2023 s nálezem trvající téměř kompletní remise (stacionární atelektáza plicního pole vlevo).
Reference
1 SPC přípravku KEYTRUDA® 25 mg/ml koncentrát pro infuzní roztok na www.sukl.cz.
2 SPC přípravku KEYTRUDA® 395 mg a 790 mg injekční roztok na www.sukl.cz.